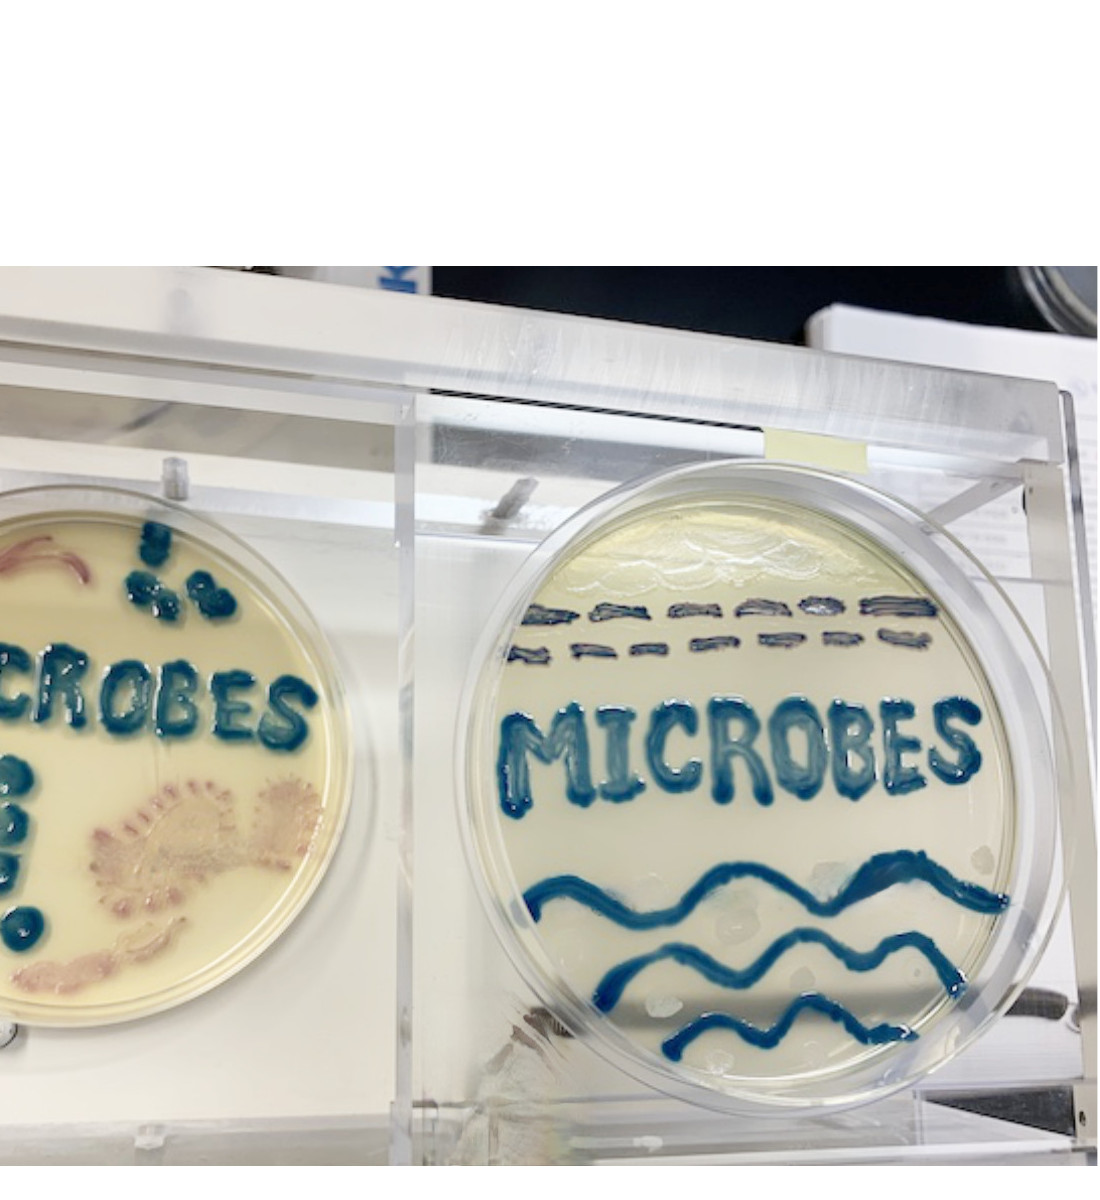
微生物学講座・感染症科 | 藤田医科大学 医学部

マイストア
変更
お店で受け取る
(送料無料)
配送する
納期目安:
2025.12.08 1:1頃のお届け予定です。
決済方法が、クレジット、代金引換の場合に限ります。その他の決済方法の場合はこちらをご確認ください。
※土・日・祝日の注文の場合や在庫状況によって、商品のお届けにお時間をいただく場合がございます。
Microbiology(微生物学)~海外医学部を6年で卒業プロジェクト~ Microbiology(微生物学)~海外医学部を6年で卒業プロジェクトの詳細情報
Microbiology(微生物学)~海外医学部を6年で卒業プロジェクト。微生物プラチナアトラス | 佐々木雅一, 岡 秀昭, 岡 秀昭 |本 | 通販。Amazon | Brock Biology of Microorganisms, Global Edition | Madigan。Summa Cum Laude ~海外医学部を6年で卒業プロジェクト~Microbiology(微生物学)です。ASM臨床微生物学検査法ハンドブック(第5版・全5巻) | 教育と研究の未来。13時間で微生物を全体を網羅。最新原本サピックス4年2024年10月度マンスリー~2024年12月度マンスリー。Final Exam 対策に最適です。TAC公務員講座 総合本科生教材一式 2022年合格目標。細菌、ウィルス、真菌、原虫を含みます。希少 数学特進講座 高1数学 前期 後期 2冊セット 鉄緑会。A. Bacteria01. Gram + Coccus Species02. Gram + Spore forming Species03. Gram+ Rods.04. Acid Fast Species05. Gram - Coccus Species06. G- Rods.07. Zoonosis08. Mycobacterium Species09. Spirochetes10. AtypicalsB. Virus (44 species)01. DNA viruses02. RNA + strand viruses03. RNA - strand virusesC. Fungi (12 species)01. Systemic Mycosis02. Cutaneious Mycosis.03. Oppotunisitc MycosisD. Parasites (20 species)01. Protozoa02. Helmints対象者:▪米国、ハンガリー、チェコなど英語で医学を学ぶ方▪特に、海外医学部を6年で卒業したい方▪これから医学部留学される方 (本教材で留学前から学習を始められます)▪海外医学部のレベル感を知りたい方(受験前に1科目程度見ておいていいかもしれません)▪留学中で、留年中の方▪USMLE対策。2025年度 社会保険労務士 社労士 基礎講座 過去問講座 フォーサイト。日本の医師国家試験対策(※)▪上記のような学生の親御さん。クレアール社会保険労務士講座2024/2025 テキスト問題集など。(※ どこの国に行っても医学的に重要な点は基本的に同じです。まんがで身につくめざせ!あしたの算数王 10冊セット。著者は日本の国試も半年で合格していますが、日本の国試対策にもとても役に立ったと思います。同志社大学 入試問題集。)言語: Full English.海外医学部6年で卒業プロジェクトについては、doc.uk.to/m/6/ をご覧ください。【最終値下げ】本試験過去問題集 東京都Ⅰ類B (行政・一般方式) 6冊セット。(Browserで開いてください。京大文系数学 炎の100題 解答付き。)
ベストセラーランキングです
近くの売り場の商品
カスタマーレビュー
オススメ度 4.8点
現在、7028件のレビューが投稿されています。